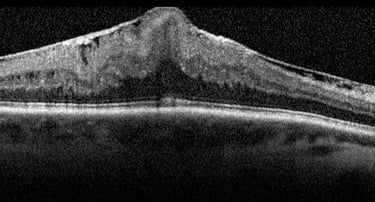

DIABETES
& Retina
Retinal conditions such as diabetic retinopathy, macular degeneration, and other serious retinal issues like epiretinal membranes, macular holes, cystoid macular edema, and retinal tears or detachments can lead to permanent vision loss if left untreated. Early detection and management are key to preserving your eyesight. In this blog post, we’ll dive into diabetic retinopathy, macular degeneration, and other important retinal conditions to help you understand symptoms, risk factors, and the latest treatment options.
What is Diabetic Retinopathy?
Diabetic retinopathy is an eye condition that affects people with diabetes. It occurs when high blood sugar levels damage the blood vessels in the retina, leading to leakage, bleeding, and in severe cases, vision loss. There are two main stages of diabetic retinopathy:
Non-Proliferative Diabetic Retinopathy (NPDR): The early stage where blood vessels in the retina become weak and may leak fluid, but vision may remain unaffected.
Proliferative Diabetic Retinopathy (PDR): The advanced stage, characterized by the growth of abnormal blood vessels that can leak and cause retinal scarring, leading to vision impairment or blindness.
Diabetic retinopathy can also lead to diabetic macular edema (DME), a condition where fluid builds up in the macula, leading to blurry central vision.
What is Macular Degeneration?
Macular degeneration (AMD) is a condition that affects the macula, the central part of the retina responsible for sharp, clear vision. AMD can lead to the gradual loss of central vision, affecting daily tasks like reading and driving. There are two types of macular degeneration:
Dry Macular Degeneration: The more common form of AMD, where the macula deteriorates over time, leading to slow vision loss.
Wet Macular Degeneration: More severe, wet AMD occurs when abnormal blood vessels grow under the retina, leaking fluid and causing scarring of the macula. This can lead to rapid and severe vision loss if untreated.
Other Serious Retinal Conditions
Beyond diabetic retinopathy and macular degeneration, several other conditions can affect the retina and threaten your vision. Let’s take a closer look at these conditions:
1. Epiretinal Membranes
An epiretinal membrane (also called a macular pucker) is a thin layer of tissue that forms on the surface of the retina, specifically over the macula. This membrane can cause the macula to wrinkle or distort, resulting in blurred or distorted vision. Epiretinal membranes are often age-related and can occur without noticeable symptoms in the early stages. However, as the condition progresses, patients may experience:
Blurred or distorted central vision
Wavy or straight lines appearing bent
Difficulty reading or seeing fine details
Treatment for epiretinal membranes may involve vitrectomy surgery to remove the membrane and restore vision if it is causing significant visual impairment.
2. Macular Holes
A macular hole is a small tear or break in the macula, the part of the retina responsible for central vision. Macular holes often develop due to aging, trauma, or underlying retinal conditions. Symptoms include:
Blurry or distorted central vision
A small dark spot or blank area in the center of vision
Difficulty reading or performing tasks requiring sharp central vision
In most cases, macular holes can be treated with surgery (such as vitrectomy) to repair the hole and improve vision. Early intervention can prevent further damage to the retina.
3. Cystoid Macular Edema (CME)
Cystoid macular edema (CME) is a condition in which fluid accumulates in the macula, causing swelling and blurred central vision. CME is often a complication of other retinal conditions like diabetic retinopathy, macular degeneration, or after eye surgery such as cataract surgery. Symptoms include:
Blurry or fluctuating central vision
Distorted or wavy lines
Sensitivity to light
CME can often be managed with medications such as steroids or anti-VEGF injections, which reduce swelling and improve vision. If the condition persists, additional treatments or surgery may be required.
4. Retinal Tears and Retinal Detachments
Retinal tears and retinal detachments are serious conditions that occur when the retina becomes torn or separated from the underlying tissue. These conditions require immediate medical attention to prevent permanent vision loss.
Retinal Tears: A retinal tear occurs when the retina is pulled or stretched too far, causing a break in the retinal tissue. Tears may lead to retinal detachment if left untreated.
Retinal Detachments: A retinal detachment occurs when the retina pulls away from the underlying tissue, leading to the loss of vision.
Symptoms of retinal tears or detachments include:
Sudden flashes of light
The appearance of floaters or dark spots in your vision
A shadow or curtain in your field of vision
Treatment for retinal tears or detachment often requires laser therapy, cryotherapy, or surgical intervention such as vitrectomy or scleral buckle surgery to reattach the retina.
Symptoms and Risk Factors for Retinal Conditions
While some retinal conditions may develop with few or no symptoms in the early stages, others may cause noticeable visual changes.
Here are some common symptoms to watch for:
Blurred vision or sudden vision loss
Flashes of light or new floaters in your vision
Distorted vision or straight lines appearing wavy
Central vision loss, making it hard to read or recognize faces
Risk Factors for retinal conditions include:
Age: As we age, the risk of developing macular degeneration, epiretinal membranes, and macular holes increases.
Diabetes: People with diabetes are at higher risk for developing diabetic retinopathy and diabetic macular edema.
Family History: A family history of retinal conditions can increase your likelihood of developing similar issues.
High Blood Pressure or High Cholesterol: These conditions can damage blood vessels in the retina and increase the risk of retinal detachment and diabetic retinopathy.
Smoking: Smoking accelerates the progression of many retinal conditions, including macular degeneration.
How Are Retinal Conditions Diagnosed?
Retinal conditions can be diagnosed during a comprehensive eye exam, which may include the following:
Dilated Eye Exam: Your eye doctor will use drops to dilate your pupils and examine the retina for signs of damage or disease.
Fluorescein Angiography: A dye is injected into your arm, and photographs are taken of the retina to reveal blood vessel leaks or abnormalities.
Optical Coherence Tomography (OCT): This non-invasive imaging test provides detailed cross-sectional images of the retina to detect swelling, fluid, or retinal tears.
Amsler Grid: This simple test helps identify visual distortions, which may be a sign of macular degeneration or other retinal conditions.
Treatment Options for Retinal Conditions
Treatment for retinal conditions depends on the type and severity of the condition:
Diabetic Retinopathy: Treatment options include laser therapy, anti-VEGF injections, and corticosteroid injections to prevent further damage and swelling.
Macular Degeneration: Anti-VEGF injections, laser therapy, and nutritional supplements (AREDS formula) can slow progression and preserve vision.
Epiretinal Membranes and Macular Holes: These conditions may require vitrectomy surgery to remove the epiretinal membrane or repair a macular hole.
Cystoid Macular Edema: Treatment often includes steroid injections or anti-VEGF therapy to reduce swelling and improve vision.
Retinal Tears and Retinal Detachments: Treatment often requires laser therapy, cryotherapy, or surgical repair to reattach the retina and prevent vision loss.
Preventing Retinal Conditions
While some risk factors like age and genetics cannot be controlled, there are lifestyle changes and strategies to help reduce your risk of retinal conditions:
Manage Diabetes: Keep your blood sugar levels in check to reduce the risk of diabetic retinopathy.
Quit Smoking: Smoking accelerates retinal damage, so quitting can significantly lower your risk of many eye diseases.
Monitor Blood Pressure and Cholesterol: Keep these factors under control to protect your retinal health.
Schedule Regular Eye Exams: Early detection is essential for preventing permanent vision loss. If you're over 60, have diabetes, or have a family history of retinal conditions, make sure to get regular eye exams.
Final Thoughts on the Treatment and Management of Retinal Conditions
Retinal conditions such as diabetic retinopathy, macular degeneration, epiretinal membranes, macular holes, cystoid macular edema, and retinal tears can cause significant vision loss if left untreated. However, with early detection and proper treatment, it's possible to manage these conditions and preserve your eyesight.
If you experience any symptoms or are at higher risk, schedule a comprehensive eye exam with one of our eye care providers. At MD Eye Center, we're dedicated to providing personalized care and advanced treatments to protect your vision and eye health.
Contact us today to learn more about how we can help you maintain healthy vision for years to come.
Understanding Diabetic Retinopathy, Macular Degeneration, and Other Retinal Conditions:
Protect Your Vision with Early Detection

© 2025. All rights reserved.
